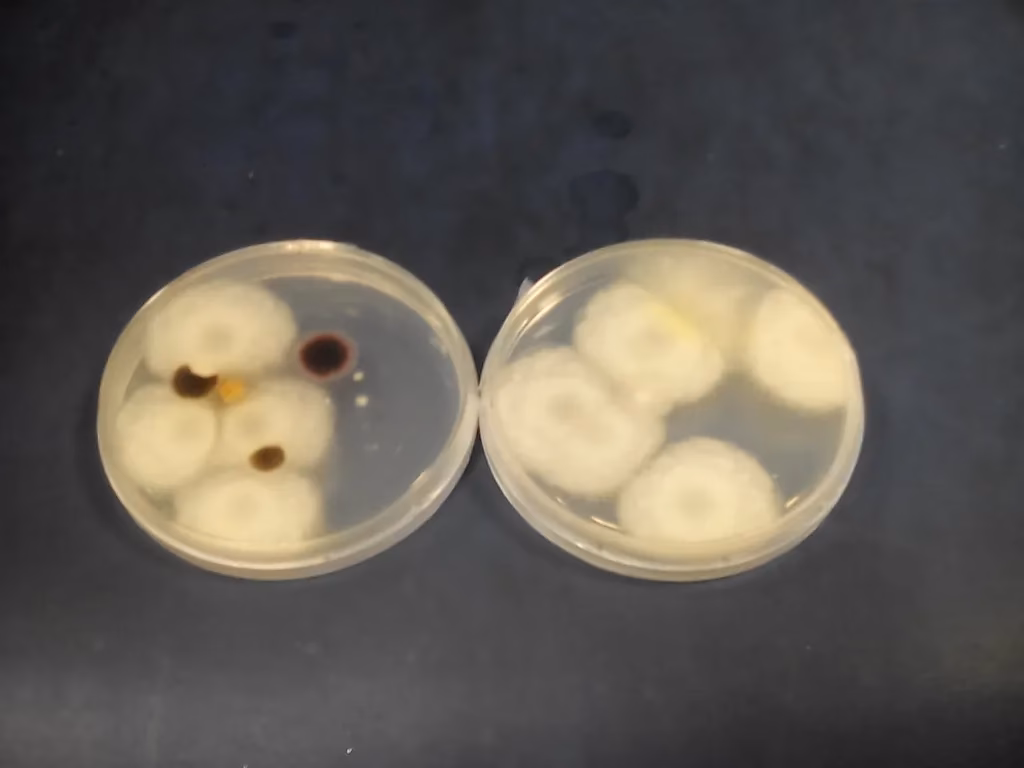
¿Cuáles son las poblaciones mixtas del proceso de compostaje?

06/07/2019
Cuando miramos una pila de compost, a menudo solo vemos restos de vegetales, hojas secas y otros materiales orgánicos en descomposición. Sin embargo, bajo esa apariencia tranquila, bulle un universo de vida microscópica trabajando sin descanso. El compostaje no es un proceso químico inerte, sino un vibrante ecosistema en miniatura, impulsado por una compleja comunidad de microorganismos. Son ellos, las poblaciones mixtas, los verdaderos artífices de la transformación de residuos en un recurso invaluable para nuestros suelos. En este artículo, nos sumergiremos en este mundo oculto para conocer a sus protagonistas.
¿Qué son las Poblaciones Mixtas del Compostaje?
El término "poblaciones mixtas" se refiere a la diversa comunidad de microorganismos que coexisten y colaboran para descomponer la materia orgánica. No se trata de una sola especie, sino de un consorcio dinámico donde diferentes grupos toman el relevo en distintas fases del proceso. Esta colaboración es esencial, ya que cada grupo está especializado en descomponer diferentes tipos de compuestos. Los tres grupos más importantes y determinantes en este proceso son las bacterias, los actinomicetos y los hongos filamentosos.
Las Bacterias: Las Reinas Indiscutibles del Compost
Si el compostaje fuera un reino, las bacterias serían sin duda la población dominante. Constituyen entre el 80% y el 90% de toda la biomasa microbiana presente en el compost, lo que las convierte en las trabajadoras más numerosas y eficientes del proceso. Su pequeño tamaño y su increíblemente rápida tasa de reproducción les permiten colonizar rápidamente la materia orgánica fresca y comenzar el trabajo de descomposición.
El papel de las bacterias varía según la etapa del compostaje, que se caracteriza principalmente por la temperatura:
- Fase Mesófila (Temperatura moderada: 20-45°C): Al inicio del proceso, las bacterias mesófilas son las primeras en actuar. Se alimentan de los compuestos más sencillos y fácilmente degradables, como azúcares y almidones. Su actividad metabólica genera calor, lo que provoca un aumento gradual de la temperatura en la pila de compost.
- Fase Termófila (Alta temperatura: 45-70°C): Este es el corazón del proceso de compostaje. A medida que la temperatura sube, las bacterias mesófilas mueren o se vuelven inactivas, dando paso a las bacterias termófilas, amantes del calor. Esta fase termófila es crucial por dos razones. Primero, estas bacterias descomponen materiales más complejos como grasas, proteínas y celulosas a una velocidad vertiginosa. Segundo, las altas temperaturas alcanzadas (idealmente por encima de 55°C) son fundamentales para la higienización del compost, ya que eliminan patógenos, parásitos y semillas de malas hierbas.
- Fase de Enfriamiento y Maduración: Una vez que los compuestos más complejos se han degradado, la actividad bacteriana disminuye y la pila de compost comienza a enfriarse. En esta etapa, las bacterias mesófilas vuelven a tomar el control para terminar de procesar la materia restante, dando inicio a la fase de maduración, donde se forma el humus estable.
Actinomicetos: Los Arquitectos del Aroma a Tierra
A medida que el compost madura y se enfría, otro grupo de microorganismos entra en escena: los actinomicetos. Estos son un tipo de bacterias que crecen formando filamentos ramificados, similares a los hongos, lo que les permite penetrar en materiales más duros. Son los responsables de descomponer compuestos muy resistentes que las bacterias iniciales no pudieron procesar, como la lignina (el componente leñoso de las plantas), la quitina y otras celulosas complejas.
Una de las características más reconocibles del trabajo de los actinomicetos es el característico y agradable "olor a tierra mojada" que tiene el compost maduro y de buena calidad. Este aroma es producido por una sustancia química llamada geosmina, secretada por estos microorganismos. Por lo tanto, cuando tu compost huele a bosque, es una señal inequívoca de que los actinomicetos han hecho bien su trabajo y el proceso de maduración está avanzado.
Hongos Filamentosos: Los Especialistas en Materia Compleja
Junto a los actinomicetos, los hongos filamentosos son los otros grandes descomponedores de materiales resistentes. A diferencia de muchas bacterias, los hongos pueden tolerar condiciones de pH más ácido y una menor humedad, lo que les permite prosperar en diferentes momentos del compostaje. Su estructura de hifas (filamentos) les permite extenderse a través de la pila de compost y secretar potentes enzimas que descomponen la celulosa y, especialmente, la lignina, una de las moléculas orgánicas más difíciles de degradar en la naturaleza.
Los hongos son particularmente visibles en las etapas intermedias y de maduración, a menudo apareciendo como una red de filamentos blancos o grises en la pila. Su labor es fundamental para convertir los restos leñosos y fibrosos en materia orgánica más simple, preparando el terreno para que otros microorganismos continúen el proceso y contribuyendo a la formación de una estructura de suelo estable y rica en nutrientes.
Tabla Comparativa de Microorganismos del Compost
| Microorganismo | Rol Principal | Fase de Actividad | Sustratos Preferidos | Característica Distintiva |
|---|---|---|---|---|
| Bacterias | Descomposición rápida, generación de calor, higienización. | Todas las fases, especialmente Mesófila y Termófila. | Azúcares, almidones, proteínas, grasas. | Son las más numerosas (80-90%). Responsables de la fase de alta temperatura. |
| Actinomicetos | Descomposición de compuestos complejos. | Enfriamiento y Maduración. | Celulosa, lignina, quitina. | Producen el característico "olor a tierra mojada" (geosmina). |
| Hongos Filamentosos | Descomposición de materiales muy resistentes y leñosos. | Intermedia y Maduración. | Lignina, celulosa. | Toleran pH más ácidos y son visibles como redes de filamentos blancos. |
La Sinergia Microbiana: Un Ecosistema en Equilibrio
Es crucial entender que estos tres grupos no compiten entre sí, sino que trabajan en una sucesión ecológica perfectamente orquestada. Las bacterias inician el proceso y elevan la temperatura, creando las condiciones para que otras bacterias termófilas actúen. A medida que los materiales más simples se agotan, los hongos y actinomicetos toman el relevo para descomponer las fibras más duras. El éxito del compostaje depende del equilibrio de esta comunidad, el cual se mantiene proporcionando las condiciones adecuadas: una buena relación carbono/nitrógeno, humedad correcta y, sobre todo, suficiente oxígeno para favorecer a estos microorganismos aeróbicos.
Comprender el papel de estas poblaciones mixtas nos permite apreciar el compostaje no solo como una técnica de reciclaje, sino como un proceso biológico que imita a la naturaleza para crear vida a partir de la descomposición. Fomentar esta biodiversidad microscópica es la clave para obtener un compost de alta calidad, rico y estable, capaz de regenerar la salud de nuestros suelos.
Preguntas Frecuentes (FAQ)
¿Necesito añadir estos microorganismos a mi compostera?
No, en la gran mayoría de los casos no es necesario. Estos microorganismos son ubicuos en el ambiente: se encuentran en el suelo, en los propios restos orgánicos, en el aire y en el agua. Simplemente proporcionando las condiciones adecuadas de humedad, aireación y una mezcla equilibrada de materiales verdes (nitrógeno) y marrones (carbono), ellos colonizarán la pila de forma natural y comenzarán su trabajo.
¿Por qué mi compost huele mal (a podrido o amoníaco)?
Un mal olor es una señal de que el ecosistema microbiano está desequilibrado. Un olor a podrido o a huevos podridos generalmente indica una falta de oxígeno, lo que favorece a las bacterias anaeróbicas (que no necesitan aire) en lugar de las aeróbicas. Estas bacterias producen compuestos malolientes como el ácido sulfhídrico. La solución es voltear el compost para airearlo. Un fuerte olor a amoníaco indica un exceso de material rico en nitrógeno (verdes). La solución es añadir más material rico en carbono (marrones), como hojas secas, cartón o serrín.
¿Son peligrosos estos microorganismos?
La inmensa mayoría de los microorganismos del compost son beneficiosos y no suponen un riesgo para la salud. De hecho, una de las funciones más importantes de la fase termófila (alta temperatura) es precisamente la de eliminar microorganismos patógenos que podrían estar presentes en los residuos, como E. coli o Salmonella. Sin embargo, siempre es recomendable usar guantes al manipular el compost y lavarse bien las manos después, como medida de higiene básica.
Si quieres conocer otros artículos parecidos a Microorganismos del Compostaje: La Vida Oculta puedes visitar la categoría Ecología.

